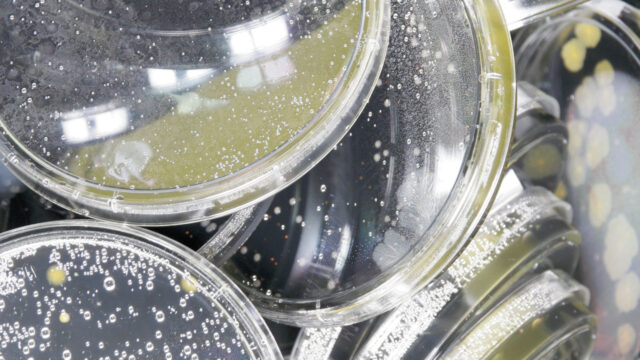
Petrischalen met vloeistoffen gestappeld voor microbiologische analyses

Chemische analyse

Onze geaccrediteerde laboratoria zijn volledig ingericht op het uitvoeren van luchtanalyses voor de binnen- en buitenomgeving. Daarmee waarborgen wij optimale kwaliteit en betrouwbaarheid.
Wij maken gebruik van gevalideerde analyse- en onderzoeksmethoden voor arbo- en milieuwetgeving. U krijgt een heldere rapportage met concrete aanbevelingen voor verbetering.
Korte doorlooptijd
In tegenstelling tot andere laboratoria voeren wij de metingen en analyses in eigen beheer uit. Onze werkwijze kenmerkt zich door dubbele controles, korte doorlooptijden en flexibiliteit. We maken gebruik van genormeerde bemonsteringstechnieken. Ook voldoen onze laboratoria aan de accreditatiecriteria voor testlaboratoria, zoals vastgelegd in NEN-EN-ISO/IEC 17025. Onze geaccrediteerde verrichtingen kunt u inzien op www.rva.nl onder scope nummer L192.
Spoedanalyse
Bij ons bent u verzekerd van een doorlooptijd van vijf werkdagen. Heeft u een spoedanalyse? Dan voeren we een analyse binnen 24 uur voor u uit. We lezen de analyseresultaten automatisch in ons LIMS-systeem in. De keten van dataoverdracht is hierdoor gesloten, van monsterregistratie tot en met rapportage.

Kwaliteitsborging
De laboratoria van Tetra Tech werken volgens een kwaliteitssysteem dat uitgaat van de hoogste kwaliteitsnormen. Zij voldoen aan de criteria die zijn vastgelegd in NEN-EN-ISO/IEC 17025 en ISO 9001. Een overzicht van onze accreditaties vindt u ook terug op de site van de Raad voor Accreditatie onder registratienummers L192.